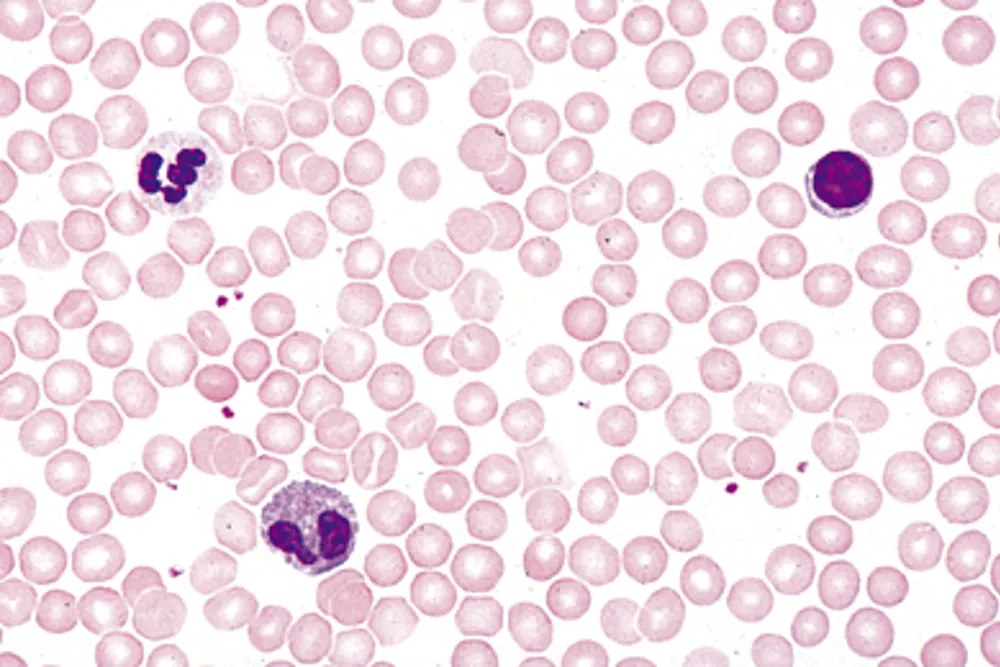

Product Details
Human blood, microscope slide
The microslide shows a blood smear of human blood that has been fixed and stained so that the different blood cells can be clearly distinguished. The red blood cells appear red, while the white blood cells are seen in purple-blue shades with different sizes and nuclear types. The slide provides a clear insight into the composition of the blood and makes it possible to work with both the structure and function of the individual cell types.
Description
Use of the product
In teaching, the micropreparation can be used in biology and science to study the structure and function of blood. Students can examine the difference between red and white blood cells, gain insight into the cells of the immune system and practice microscopy techniques. In secondary education, it can be included in courses on the circulatory system and the body’s defense system, while at the upper secondary level and in special education it can be used for more detailed analyses, e.g. cell counting or comparison with other tissue types.
The preparation is also relevant in health education and laboratory environments, as it provides a simple and concrete opportunity to practice observing the cellular components of the blood, which constitute a central part of medical and biological practice.